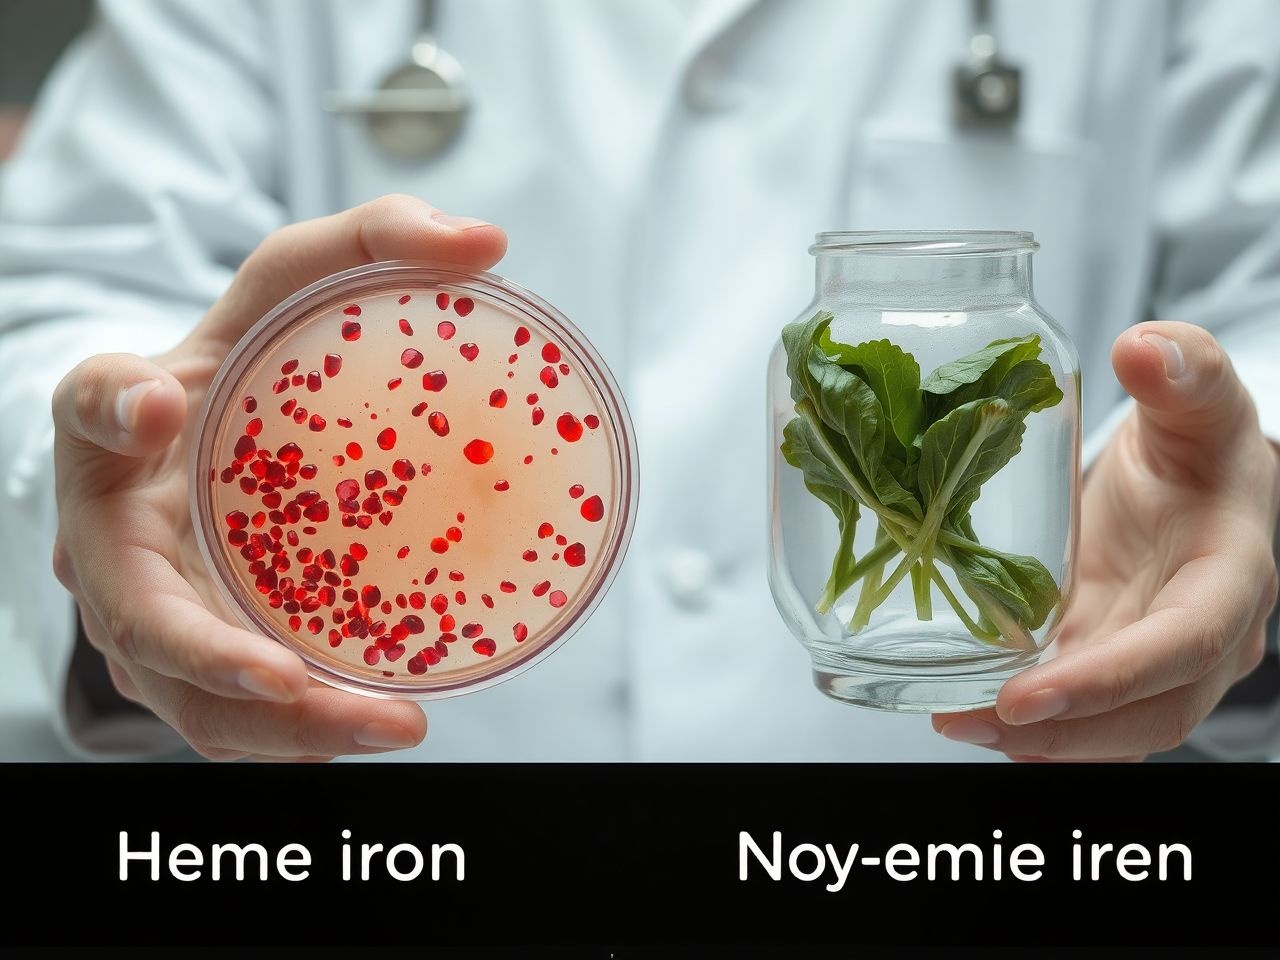

A cikk tartalma Show
A vas egy olyan esszenciális ásványi anyag, amely nélkülözhetetlen az emberi szervezet optimális működéséhez és a mindennapi vitalitáshoz. Bár sokan csak a vérszegénységgel hozzák összefüggésbe, szerepe ennél jóval szerteágazóbb és mélyrehatóbb. A vas nem csupán egy egyszerű mikroelem; valójában az élet egyik alapköve, amely számos biokémiai folyamatban vesz részt, a sejtek energiaellátásától kezdve az immunrendszer működéséig.
Az emberi test körülbelül 3-4 gramm vasat tartalmaz, melynek jelentős része a vérben, azon belül is a vörösvértestekben található hemoglobin molekulákhoz kötve végzi létfontosságú munkáját. Egy kisebb rész a mioglobinban, az izmok oxigéntároló fehérjéjében, míg a maradék enzimrendszerek alkotóelemeként vagy raktározott formában (ferritinként) van jelen. Ez az ásványi anyag tehát nemcsak az oxigén szállításáért felel, hanem kulcsszerepet játszik az energiaszint fenntartásában, a kognitív funkciók optimalizálásában és a betegségek elleni védekezésben is.
Az oxigénszállítás mestere: a hemoglobin és a mioglobin
A vas legismertebb és talán legfontosabb funkciója az oxigénszállítás. A vörösvértestekben található hemoglobin fehérje tartalmaz vasat, amely képes reverzibilisen megkötni az oxigént a tüdőben, majd eljuttatni azt a test minden egyes sejtjéhez és szövetéhez. Ez a folyamat alapvető a sejtek energiatermeléséhez, hiszen oxigén nélkül az anyagcsere lelassul, és a szervezet nem tudja hatékonyan előállítani a működéséhez szükséges energiát.
A hemoglobin minden egyes molekulája négy vasatomot tartalmaz, és mindegyik vasatom egy oxigénmolekulát képes megkötni. Amikor a vér oxigéndús, a hemoglobin telített, és a tüdőből a szívbe, majd onnan a test többi részébe áramlik. A szövetekben az oxigén leadódik, és a hemoglobin visszatér a tüdőbe, hogy újra feltöltődjön. Ez a folyamatos ciklus biztosítja, hogy minden sejt elegendő oxigénhez jusson a túléléshez és a hatékony működéshez.
Hasonlóképpen, a mioglobin az izmokban található oxigéntároló fehérje, amely szintén vasat tartalmaz. A mioglobin feladata, hogy oxigént raktározzon az izomsejtekben, különösen intenzív fizikai aktivitás során, amikor az oxigénigény hirtelen megnő. Ez biztosítja, hogy az izmok ne merüljenek ki azonnal, és képesek legyenek tovább dolgozni, még oxigénhiányos körülmények között is. A vas hiánya tehát közvetlenül befolyásolja az izmok teljesítményét és az állóképességet.
„A vas nem csupán egy nyomelem, hanem a szervezet oxigénellátásának kulcsa, amely nélkül a sejtek nem jutnának elegendő energiához a mindennapi működéshez.”
Az energia-anyagcsere motorja: vas és az ATP termelés
Az energia-anyagcsere folyamatai szorosan összefüggnek a vas jelenlétével. A sejtek fő energiaforrása az adenozin-trifoszfát (ATP), amelynek előállítása a mitokondriumokban, a sejtek „erőműveiben” történik. A vas számos enzimnek, köztük a citokrómoknak is nélkülözhetetlen alkotóeleme, amelyek az elektrontranszport láncban játszanak kulcsszerepet. Ez a lánc felelős az ATP nagyrészének termeléséért.
Amikor a vas szintje alacsony, az ATP termelés hatékonysága csökken, ami általános fáradtsághoz, gyengeséghez és csökkent energiaszinthez vezet. Az anyagcsere folyamatok lelassulnak, és a szervezet nehezebben tudja feldolgozni a tápanyagokat. Ez a hatás nemcsak a fizikai teljesítményt befolyásolja, hanem a mentális éberséget és a koncentrációs képességet is.
A vas tehát közvetlenül részt vesz a glükóz és a zsírsavak energiává alakításában. Enélkül a folyamat nélkül a táplálékból származó energia nem hasznosulna megfelelően, ami azt jelentené, hogy még elegendő kalóriabevitel mellett is energiahiányos állapotba kerülhetnénk. Ezért a megfelelő vasszint fenntartása alapvető fontosságú a folyamatos és stabil energiaszint biztosításához.
Az immunrendszer pajzsa: vas szerepe a védekezésben
Az immunrendszer hatékony működéséhez is nélkülözhetetlen a vas. Számos immunsejt, például a limfociták és a makrofágok működése függ a megfelelő vasszinttől. A vas részt vesz az immunválasz kialakításában, segít a kórokozók elleni küzdelemben és a gyulladásos folyamatok szabályozásában.
A vas hiánya gyengíti az immunrendszert, fogékonyabbá teszi a szervezetet a fertőzésekre, és lassítja a gyógyulási folyamatokat. A vas alacsony szintje esetén a fehérvérsejtek, amelyek a szervezet első védelmi vonalát képezik, nem tudnak megfelelően szaporodni és működni. Ez azt jelenti, hogy a vashiányos egyének gyakrabban betegedhetnek meg, és a betegségeik is súlyosabb lefolyásúak lehetnek.
Fontos azonban megjegyezni, hogy a vas túlzott mennyisége sem ideális az immunrendszer számára. A túl sok vas elősegítheti bizonyos baktériumok szaporodását, és fokozhatja a gyulladást. Ezért a vasbevitelnek egyensúlyban kell lennie, sem a hiány, sem a túlzott bevitel nem kedvez az optimális immunműködésnek. A szervezet rendkívül finom mechanizmusokkal szabályozza a vas felszívódását és raktározását éppen ezen egyensúly fenntartása érdekében.
A kognitív funkciók és az idegrendszer támasza

Az agy és az idegrendszer megfelelő működéséhez elengedhetetlen a vas. A vas kulcsszerepet játszik a neurotranszmitterek, például a dopamin, a noradrenalin és a szerotonin szintézisében. Ezek a kémiai hírvivők felelősek a hangulat, a koncentráció, a memória és az alvás szabályozásáért.
A vashiányos állapotok, különösen gyermekkorban, súlyosan befolyásolhatják a kognitív fejlődést és a tanulási képességet. Felnőtteknél a vas alacsony szintje memóriazavarokhoz, csökkent koncentrációs képességhez, ingerlékenységhez és akár depressziós tünetekhez is vezethet. Az agy rendkívül érzékeny az oxigénellátás ingadozásaira, és mivel a vas az oxigénszállításban kulcsszerepet játszik, hiánya közvetlenül rontja az agy oxigénellátását is.
A vas emellett részt vesz a mielinhüvely képzésében is, amely az idegsejtek axonjait szigeteli, és biztosítja az idegimpulzusok gyors és hatékony továbbítását. A mielinhüvely károsodása súlyos neurológiai problémákhoz vezethet. Ezért a megfelelő vasszint fenntartása létfontosságú az idegrendszer egészségéhez és a szellemi teljesítőképesség megőrzéséhez.
„A vas nemcsak a test, hanem az elme egészségének is alapja. Hiánya tompítja a gondolkodást, rontja a memóriát, és befolyásolja a hangulatot.”
A vashiány: néma járvány a modern társadalomban
A vashiány a világ leggyakoribb táplálkozási hiánybetegsége, amely becslések szerint a világ népességének mintegy 25%-át érinti. Különösen gyakori a fejlődő országokban, de a fejlett társadalmakban sem ritka, főleg a nőknél, gyermekeknél és vegetáriánusoknál. Gyakran nevezik „néma járványnak”, mert a kezdeti tünetek enyhék és nem specifikusak, így sokan észre sem veszik, hogy vashiányban szenvednek.
A vashiány akkor alakul ki, ha a szervezet vaskészletei kimerülnek, és nem képes elegendő vasat biztosítani a normális fiziológiai folyamatokhoz. Ez történhet elégtelen vasbevitellel, fokozott vasvesztéssel (pl. vérzés miatt), vagy a vas felszívódásának zavarával. Kezeletlenül a vashiány súlyosabb állapotba, vashiányos vérszegénységbe torkollhat, amely már markánsabb tünetekkel jár.
A vashiány nem csupán fáradtságot okoz; hosszú távon komoly egészségügyi problémákhoz vezethet, mint például a szív- és érrendszeri terhelés, az immunrendszer gyengülése, a kognitív funkciók romlása és a terhességi komplikációk. Éppen ezért kiemelten fontos a vas megfelelő bevitelére odafigyelni, és a vas státusz rendszeres ellenőrzése, különösen a rizikócsoportok esetében.
A vashiányos vérszegénység tünetei és felismerése
A vashiányos vérszegénység (anémia) akkor alakul ki, ha a szervezet vaskészletei olyan mértékben lecsökkennek, hogy már nem tud elegendő hemoglobint termelni, ami a vörösvértestek oxigénszállító képességének romlásához vezet. A tünetek gyakran fokozatosan alakulnak ki, és sokáig enyhék lehetnek, de idővel súlyosbodnak.
Az alábbi táblázat összefoglalja a vashiányos vérszegénység leggyakoribb tüneteit:
| Tünet | Leírás |
|---|---|
| Fáradtság és gyengeség | A leggyakoribb tünet, mely az oxigénhiányos sejtek energiahiányából fakad. Állandó kimerültség érzése, még pihenés után is. |
| Sápadt bőr és nyálkahártyák | A hemoglobin hiánya miatt a vér kevésbé vörös, ami sápadtságot okozhat a bőrön, az ajkakon, az ínyen és a szemhéj belső részén. |
| Légszomj és szapora szívverés | A szívnek keményebben kell dolgoznia, hogy több oxigént juttasson a szövetekbe, ami légszomjhoz, mellkasi fájdalomhoz és palpitációhoz vezethet. |
| Szédülés és fejfájás | Az agy oxigénhiánya okozza, ami koncentrációs zavarokkal is párosulhat. |
| Hideg kezek és lábak | A rossz vérkeringés és az oxigénhiány miatt a végtagok hőmérséklete alacsonyabb lehet. |
| Törékeny körmök és hajhullás | A bőr, haj és köröm egészségéhez is vasra van szükség, hiánya törékennyé, szárazzá teszi ezeket. |
| Nyugtalan láb szindróma | Ismeretlen okból, de gyakran társul vashiányhoz, kellemetlen érzés a lábakban, ami mozgásra enyhül. |
| Étvágytalanság, ízérzés zavarai | Ritkább tünet, de előfordulhat, hogy az ízlelőbimbók is károsodnak. |
| Pica szindróma | Érthetetlen vágy nem élelmiszer jellegű anyagok (pl. jég, föld, agyag) fogyasztására. |
A tünetek észlelése esetén fontos orvoshoz fordulni, aki vérvizsgálattal (vérkép, ferritin, transzferrin szaturáció) pontosan meg tudja állapítani a vas státuszát, és szükség esetén javaslatot tesz a megfelelő kezelésre.
Kik a vashiány leginkább veszélyeztetett csoportjai?
Bár a vashiány bárkinél kialakulhat, vannak bizonyos csoportok, amelyek fokozottan ki vannak téve a veszélynek. Ezen csoportok esetében különösen fontos a megelőzés és a rendszeres ellenőrzés.
- Menstruáló nők: A havi vérzés jelentős vasvesztéssel járhat, különösen erős menstruáció esetén. Ezért a reproduktív korban lévő nők a leginkább veszélyeztetettek.
- Terhes és szoptató nők: A terhesség alatt megnő a vérvolumen, és a fejlődő magzatnak is nagy mennyiségű vasra van szüksége. A szoptatás során is vasat ad át az anya a csecsemőnek.
- Csecsemők és kisgyermekek: A gyors növekedés és fejlődés nagy vasigényt támaszt. A kizárólag anyatejjel táplált csecsemők 6 hónapos kor után kiegészítő vasra szorulhatnak, ha az anya vaskészletei alacsonyak.
- Serdülőkorúak: A pubertáskori gyors növekedés, valamint a lányoknál a menstruáció kezdete növeli a vasigényt.
- Vegetáriánusok és vegánok: A növényi alapú étrendből származó nem-heme vas nehezebben szívódik fel, mint az állati eredetű heme vas. Megfelelő tervezés nélkül könnyen kialakulhat vashiány.
- Idősek: Az életkorral csökkenhet a vas felszívódása, és gyakoriak az emésztőrendszeri problémák, amelyek befolyásolják a vas hasznosulását.
- Sportolók: Különösen az állóképességi sportolók izzadással és fokozott vörösvértest-lebomlással több vasat veszíthetnek, és a megnövekedett oxigénigény miatt is nagyobb a vasigényük.
- Krónikus betegségekben szenvedők: Gyulladásos bélbetegségek (Crohn-betegség, fekélyes vastagbélgyulladás), vesebetegségek, krónikus vérzést okozó állapotok (pl. fekélyek, aranyér) mind növelik a vashiány kockázatát.
- Gyomor-bélrendszeri műtéten átesettek: Például gyomorgyűrű vagy bypass műtét után jelentősen romolhat a vas felszívódása.
„A vashiány nem válogat, de bizonyos életszakaszok és életmódbeli tényezők jelentősen növelik a kockázatot. A tudatosság és a megelőzés kulcsfontosságú.”
A vasforrások labirintusa: heme és nem-heme vas
A vasat két fő formában találjuk meg az élelmiszerekben: heme vas és nem-heme vas. Ezek felszívódása és biológiai hasznosulása jelentősen eltér egymástól, ami fontos szempont az étrend megtervezésénél.
Heme vas
A heme vas állati eredetű élelmiszerekben található meg, és a hemoglobinhoz, illetve mioglobinhoz kötött formában van jelen. Ez a vasforma kiválóan szívódik fel a szervezetben, 20-35%-os arányban. Fő forrásai a következők:
- Vörös húsok: marha, sertés, bárány
- Szárnyasok: különösen a sötét húsú részek (pl. csirkecomb)
- Halak és tenger gyümölcsei: tonhal, lazac, osztriga, kagyló
- Belsőségek: máj (kiemelkedően magas vastartalommal)
Nem-heme vas
A nem-heme vas mind növényi, mind állati eredetű élelmiszerekben megtalálható, de felszívódása lényegesen alacsonyabb, mindössze 2-20% közötti. Ennek oka, hogy felszívódását számos tényező befolyásolja, mind gátló, mind serkentő irányban. Főbb forrásai:
- Hüvelyesek: lencse, bab, csicseriborsó, szója
- Teljes kiőrlésű gabonák: zab, barna rizs, quinoa
- Sötétzöld leveles zöldségek: spenót, kelkáposzta, brokkoli
- Magvak és diófélék: tökmag, szezámmag, kesudió
- Aszalt gyümölcsök: mazsola, aszalt szilva, sárgabarack
- Tojás
- Vashoz dúsított élelmiszerek: reggelizőpelyhek, kenyerek
A nem-heme vas felszívódásának optimalizálása kulcsfontosságú, különösen a vegetáriánus és vegán étrendet követők számára. Ennek módjairól a következő fejezetben olvashatunk.
A vas felszívódásának optimalizálása: tippek és trükkök
A vas bevitele önmagában nem elegendő; legalább ilyen fontos a megfelelő felszívódás. Számos tényező befolyásolja, hogy mennyi vasat tud hasznosítani a szervezet az elfogyasztott élelmiszerekből. Íme néhány bevált stratégia az optimalizálásra:
Felszívódást segítő tényezők:
- C-vitamin: Az egyik leghatékonyabb vas felszívódást serkentő anyag. A C-vitamin a nem-heme vasat egy könnyebben felszívódó formává alakítja. Érdemes a vasban gazdag növényi élelmiszereket C-vitaminban gazdag forrásokkal (pl. paprika, citrusfélék, brokkoli, eper) együtt fogyasztani.
- Heme vas források: A heme vas (hús, hal, baromfi) nemcsak önmagában szívódik fel jobban, hanem javítja a nem-heme vas felszívódását is, ha ugyanabban az étkezésben fogyasztjuk őket. Ezt nevezik “húsfaktor” hatásnak.
- Savanyú környezet: A gyomor sósavja segíti a vas felszívódását. Ezért a savcsökkentő gyógyszerek hosszú távú szedése ronthatja a vas hasznosulását.
Felszívódást gátló tényezők:
- Fitátok (fitinsav): A teljes kiőrlésű gabonákban, hüvelyesekben, magvakban és diófélékben található fitátok megkötik a vasat, gátolva annak felszívódását. Az áztatás, csíráztatás és fermentálás csökkentheti a fitátok mennyiségét.
- Oxalátok: Egyes zöldségekben, mint a spenót, sóska, rebarbara, kakaóban is megtalálható oxalátok szintén gátolhatják a vas felszívódását.
- Polifenolok és tanninok: A tea, kávé, kakaó és egyes vörösborok gazdagok polifenolokban és tanninokban, amelyek jelentősen csökkenthetik a vas felszívódását. Érdemes ezeket az italokat a vasban gazdag étkezések előtt vagy után legalább egy órával fogyasztani.
- Kalcium: A kalcium és a vas versengenek a felszívódásért. Nagy mennyiségű kalciumot (pl. tejtermékek, kalcium-kiegészítők) és vasat nem célszerű egyszerre bevinni.
- Gyógyszerek: Bizonyos gyógyszerek, például a savlekötők, protonpumpa-gátlók, tetraciklin antibiotikumok, ronthatják a vas felszívódását.
A tudatos étkezéstervezéssel jelentősen javítható a vas biológiai hasznosulása, így elkerülhető a hiányállapot. Egy kiegyensúlyozott, változatos étrend, amely figyelembe veszi ezeket a kölcsönhatásokat, a legjobb módja a megfelelő vasszint fenntartásának.
A vas túladagolása és veszélyei: amikor a több kevesebb
Bár a vashiány széles körben elterjedt probléma, fontos tudni, hogy a vas túladagolása is komoly egészségügyi kockázatokat rejt magában. A szervezetnek nincs hatékony mechanizmusa a felesleges vas kiválasztására, így az felhalmozódhat a szervekben, károsítva azokat.
A vas túladagolása leggyakrabban a következő esetekben fordul elő:
- Vaskiegészítők túlzott vagy indokolatlan szedése: Különösen veszélyes gyermekeknél, akik véletlenül nagy mennyiségű vasat tartalmazó tablettát fogyaszthatnak.
- Hemokromatózis: Egy örökletes genetikai betegség, amelyben a szervezet túlzottan sok vasat szív fel az élelmiszerekből. Kezeletlenül súlyos szervkárosodáshoz vezethet.
- Gyakori vérátömlesztés: Bizonyos betegségek (pl. thalassemia) kezelése során a gyakori vérátömlesztések vasfelhalmozódást okozhatnak.
A vas túladagolásának tünetei lehetnek az emésztőrendszeri panaszok (hányinger, hányás, hasmenés, hasi fájdalom), fáradtság, ízületi fájdalom, májkárosodás, szívproblémák, cukorbetegség, és bőrelszíneződés. Hosszú távon a szervekben felhalmozódó vas oxidatív stresszt és sejtkárosodást okozhat, növelve bizonyos krónikus betegségek, például a májrák és a szívbetegségek kockázatát.
Ezért rendkívül fontos, hogy vaskiegészítőket csak orvosi javaslatra és ellenőrzés mellett szedjünk. A vasbevitel optimalizálásakor mindig az egyensúlyra kell törekedni, elkerülve mind a hiányt, mind a túlzott bevitelt.
A vas szintjének mérése: laboratóriumi paraméterek értelmezése
A vas státuszának pontos felméréséhez nem elegendő csupán egy paraméter vizsgálata. Több laboratóriumi érték együttes értelmezése ad átfogó képet a szervezet vaskészleteiről és a vas anyagcseréjéről.
A legfontosabb paraméterek:
- Szérum ferritin: Ez a legpontosabb indikátor a szervezet vaskészleteinek megállapítására. A ferritin egy fehérje, amely a vasat raktározza a sejtekben. Alacsony szintje egyértelműen vashiányra utal, még a vérszegénység kialakulása előtt. Magas szintje gyulladásra, májbetegségre vagy vasfelhalmozódásra (hemokromatózis) is utalhat.
- Szérum vas: A vérben keringő vas mennyiségét mutatja. Ez az érték ingadozhat a nap folyamán és az étkezések hatására, ezért önmagában nem mindig megbízható a vashiány diagnózisában.
- Transzferrin: Ez a fehérje szállítja a vasat a szervezetben. Vashiány esetén a transzferrin szintje emelkedhet, mivel a szervezet több szállítófehérjét termel, hogy megpróbálja felvenni a rendelkezésre álló kevés vasat.
- Transzferrin szaturáció (TSAT): A transzferrin telítettségét mutatja, azaz, hogy a vasat szállító transzferrin molekulák hány százaléka kötött meg vasat. Alacsony TSAT (<20%) vashiányra utal.
- Teljes vaskötő kapacitás (TIBC): A transzferrin maximális vaskötő képességét jelzi. Vashiány esetén a TIBC értéke jellemzően emelkedik.
- Vérkép (CBC): Bár nem specifikusan vasra vonatkozik, a vérkép ad információt a vörösvértestekről. Vashiányos vérszegénység esetén a vörösvértestek száma, a hemoglobin szintje, valamint a vörösvértestek átlagos térfogata (MCV) csökken.
Ezen értékek komplex elemzésével az orvos pontosan meg tudja állapítani a vas státuszát, és ennek megfelelően javasolhatja a kezelést vagy a megelőző intézkedéseket. Öndiagnózis és öngyógyszerezés helyett mindig szakemberhez kell fordulni!
Vaspótlás: mikor és hogyan?

A vaspótlás szükségességét és módját mindig orvosnak kell eldöntenie a laboratóriumi eredmények és a tünetek alapján. Nem minden vashiányos állapot igényel azonnali gyógyszeres kezelést, és nem minden vérszegénység oka a vashiány.
Mikor szükséges a vaspótlás?
- Diagnosztizált vashiány: Ha a ferritin szint alacsony, és/vagy a transzferrin szaturáció is csökkent.
- Vashiányos vérszegénység: Amikor már a hemoglobin szint is a normál tartomány alá esett.
- Fokozott vasigény: Terhesség, szoptatás, intenzív növekedés (gyermekkor, serdülőkor), vagy krónikus vérvesztés (pl. erős menstruáció) esetén, ha az étrendi bevitel nem elegendő.
Hogyan történik a vaspótlás?
- Étrendi változtatások: Enyhe vashiány esetén, vagy megelőzés céljából, elsősorban vasban gazdag élelmiszerek beépítése az étrendbe, a felszívódást segítő tényezők figyelembevételével.
- Orális vaskiegészítők: A leggyakoribb kezelési mód. Különböző formákban kaphatók (pl. vas-szulfát, vas-glükonát, vas-fumarát, vas-biszglicinát). Fontos a megfelelő adagolás és a szedési útmutató betartása.
- Intravénás vaspótlás: Súlyos vashiányos vérszegénység, felszívódási zavarok (pl. gyulladásos bélbetegségek), vagy az orális vaspótlásra adott rossz válasz esetén alkalmazzák. Ez gyorsabban emeli a vasszintet, de kórházi körülmények között, orvosi felügyelet mellett történik.
Az orális vaspótlásnak lehetnek mellékhatásai, mint például székrekedés, hasmenés, hányinger vagy gyomorégés. Ezek enyhítésére javasolt az étkezés közbeni szedés (bár ez csökkentheti a felszívódást), vagy a vas-biszglicinát forma választása, amely kíméletesebb a gyomorhoz. A vas felszívódását a C-vitamin egyidejű bevitele segítheti. A kezelés időtartama jellemzően több hónap, a vaskészletek feltöltéséig.
„A vaspótlás nem öncélú, hanem egy orvosilag indokolt beavatkozás, melynek célja az optimális vasszint helyreállítása és az egészség megőrzése.”
Életmód és vas: mozgás, stressz és táplálkozás összefüggései
Az életmódunk számos eleme befolyásolhatja a vas anyagcseréjét és a szervezet vasszintjét. A táplálkozáson túl a fizikai aktivitás, a stresszkezelés és az általános egészségi állapot is hatással van erre az esszenciális mikroelemre.
Fizikai aktivitás:
Az intenzív testmozgás növelheti a vasigényt. A sportolók, különösen az állóképességi sportolók, fokozott vasvesztést tapasztalhatnak az izzadás, a vörösvértestek mechanikai sérülése (talpütés hemolízis) és a megnövekedett oxigénigény miatt. Ezért a sportolóknál gyakrabban fordul elő vashiány, és számukra különösen fontos a megfelelő vasbevitel biztosítása. Ugyanakkor a rendszeres, de nem túlzott testmozgás javítja az általános egészséget és a tápanyagok hasznosulását.
Stressz és gyulladás:
A krónikus stressz és az ezzel járó gyulladásos folyamatok befolyásolhatják a vas anyagcseréjét. A gyulladásos állapotokban a szervezet a vasat a raktárakba vonja vissza, hogy elrejtse azt a kórokozók elől. Ez az úgynevezett “funkcionális vashiány” állapotot hozhatja létre, ahol bár van elegendő vas a szervezetben, az nem hozzáférhető a hemoglobin termeléséhez. A stresszkezelés, elegendő alvás és a gyulladáscsökkentő étrend mind hozzájárulhat a vas anyagcsere egyensúlyának fenntartásához.
Táplálkozás és felszívódás:
Amint már említettük, a táplálkozás a legközvetlenebb tényező. A vasban gazdag élelmiszerek tudatos fogyasztása, a felszívódást segítő C-vitamin egyidejű bevitele, és a gátló anyagok (kávé, tea, kalcium) elkerülése a vasban gazdag étkezések körül mind alapvető fontosságú. A változatos és kiegyensúlyozott étrend biztosítja a szükséges mikrotápanyagokat, amelyek a vas hatékony hasznosulásához is hozzájárulnak.
Az életmódbeli döntések tehát jelentősen befolyásolják a vas státuszát, és az egészséges életmód hozzájárul az optimális vasszint fenntartásához és a vitalitáshoz.
A vas és a nők egészsége: különleges igények a menstruációtól a terhességig
A nők életében több olyan életszakasz is van, amikor fokozott vasigény lép fel, vagy megnő a vashiány kockázata. Ezek a tényezők a nők egészségére gyakorolt vasbevitel fontosságát még inkább kiemelik.
Menstruáció:
A havi vérzés a leggyakoribb oka a nők vashiányának. Különösen az erős menstruációval (menorrhagia) küzdő nők veszítenek jelentős mennyiségű vasat minden hónapban. Ez a krónikus vasvesztés, ha nem pótolják megfelelően, könnyen vashiányos vérszegénységhez vezethet. Fontos a megfelelő vasbevitel biztosítása étrendi úton, és szükség esetén orvosi javaslatra vaskiegészítők szedése.
Terhesség:
A terhesség alatt drámaian megnő a vasigény. A vérvolumen növekszik, és a fejlődő magzatnak, a méhlepénynek is nagy mennyiségű vasra van szüksége a növekedéshez és fejlődéshez. A vashiány terhesség alatt növelheti a koraszülés, az alacsony születési súly és a magzati fejlődési zavarok kockázatát. Ezért a terhes nőknek gyakran javasolnak rutinszerű vaspótlást, még akkor is, ha nincsenek nyilvánvaló hiánytüneteik.
Szoptatás:
A szoptatás során az anya vasat ad át a csecsemőnek, ami szintén növelheti a vasigényét. Bár a szoptató anyák vasigénye általában alacsonyabb, mint a terhes nőké, a megfelelő vasszint fenntartása továbbra is fontos az anya és a csecsemő egészsége szempontjából.
Szülés utáni időszak:
A szülés során fellépő vérveszteség szintén hozzájárulhat a vaskészletek kimerüléséhez. A szülés utáni vashiány fáradtsághoz, depresszióhoz és a gyógyulási folyamatok lassulásához vezethet. A szülés utáni időszakban is érdemes figyelni a vasbevitelre és szükség esetén ellenőrizni a vasszintet.
A nőknek tehát különösen oda kell figyelniük a vasbevitelre életük során, és rendszeresen ellenőriztetniük kell vasszintjüket, különösen a fent említett kritikus időszakokban.
A vas és a sportolók teljesítménye: az állóképesség kulcsa
A sportolók, különösen az állóképességi sportot űzők, esetében a vas kiemelten fontos szerepet játszik a teljesítményben és a regenerációban. A vashiány komolyan befolyásolhatja az edzési kapacitást és a versenyeredményeket.
Fokozott vasigény a sportban:
A sportolók vasigénye több okból is megnőhet:
- Növelt oxigénigény: Az intenzív edzés során az izmoknak több oxigénre van szükségük, amit a hemoglobin és a mioglobin szállít. A megnövekedett oxigénfelvételhez több vas szükséges.
- Vasvesztés izzadással: Az izzadás során a szervezet nemcsak vizet és elektrolitokat, hanem kis mennyiségű vasat is veszít.
- Vörösvértest-lebomlás: A mechanikai stressz (pl. futásnál a talpütés okozta hemolízis) fokozhatja a vörösvértestek lebomlását, ami vasvesztéshez vezethet.
- Gyulladás és vas: Az intenzív edzés utáni gyulladásos reakciók befolyásolhatják a vas felszívódását és hasznosulását.
A vashiány hatása a teljesítményre:
A sportolóknál jelentkező vashiányos vérszegénység, vagy akár a vérszegénység nélküli vashiány (amikor a ferritin alacsony, de a hemoglobin még normális) is jelentősen rontja a teljesítményt:
- Csökkent állóképesség: Az oxigénszállítás hatékonyságának romlása miatt az izmok hamarabb kifáradnak.
- Fáradtság és kimerültség: Az edzések nehezebbé válnak, a regeneráció lassul.
- Gyengébb immunrendszer: A sportolók hajlamosabbá válhatnak a fertőzésekre, ami edzéskiesést okoz.
- Csökkent koncentráció és motiváció: A kognitív funkciók romlása befolyásolhatja a sportpszichológiai állapotot is.
A sportolóknak ezért különösen oda kell figyelniük a vasbevitelre, és rendszeresen ellenőrizniük kell vasszintjüket. A megfelelő étrend, a C-vitaminban gazdag élelmiszerek fogyasztása, és szükség esetén orvosi felügyelet melletti vaspótlás segíthet az optimális teljesítmény fenntartásában.
A vas és a gyermekek fejlődése: az első évektől a serdülőkorig

A gyermekek fejlődésében a vas létfontosságú szerepet játszik, különösen az agy fejlődésében, a kognitív funkciókban és az immunrendszer működésében. A vashiány gyermekkorban súlyos, hosszú távú következményekkel járhat.
Csecsemőkor:
Az újszülöttek általában elegendő vaskészlettel születnek, amely az anyától kapott vasból származik. Azonban ez a készlet 4-6 hónapos korra kimerülhet. A kizárólag anyatejjel táplált csecsemőknek 6 hónapos kor után kiegészítő vasra lehet szükségük, mivel az anyatej vastartalma alacsony. A tápszerrel táplált csecsemők általában elegendő vasat kapnak, mivel a tápszerek vashoz dúsítottak. A vashiány csecsemőkorban fejlődési elmaradáshoz és kognitív károsodáshoz vezethet.
Kisgyermekkor és óvodáskor:
A gyors növekedés és a megnövekedett fizikai aktivitás miatt a kisgyermekek vasigénye magas. A válogatós étkezés, a túlzott tejfogyasztás (ami gátolja a vas felszívódását) és a kevés vasban gazdag élelmiszer bevitele gyakori oka a vashiánynak ebben a korban. A vashiány fáradtságot, ingerlékenységet, figyelemzavart és gyakori fertőzéseket okozhat.
Iskoláskor és serdülőkor:
Az iskoláskorú gyermekeknél és a serdülőknél a vasigény továbbra is magas a növekedés és a kognitív terhelés miatt. A lányoknál a menstruáció kezdete jelentősen növeli a vashiány kockázatát. A vas megfelelő szintje kulcsfontosságú a tanulási képességek, a koncentráció és az iskolai teljesítmény szempontjából. A vashiányos serdülők fáradékonyabbak, gyengébb a memóriájuk, és hajlamosabbak lehetnek a hangulati ingadozásokra.
A gyermekek vasbevitelére kiemelten fontos odafigyelni, és rendszeres orvosi ellenőrzés javasolt, különösen a rizikócsoportokba tartozóknál. A vasban gazdag, változatos étrend és szükség esetén a gyermekgyógyász által javasolt vaspótlás biztosíthatja az optimális fejlődést.
A vas és az időskor: a megőrzött vitalitásért
Az idősebb korban a vas anyagcseréje és a vasigény is változhat, ami különleges figyelmet igényel a vitalitás megőrzése érdekében. Bár az idősek vasigénye általában nem olyan magas, mint a fiatalabb nőké vagy a gyermekeké, a vashiány kockázata mégis jelentős.
Az időskori vashiány okai:
- Csökkent vasfelszívódás: Az életkor előrehaladtával a gyomor sósavtermelése csökkenhet, ami rontja a vas felszívódását.
- Krónikus betegségek: Az idősebb korban gyakoribb krónikus betegségek (pl. gyulladásos bélbetegségek, vesebetegségek, szívbetegségek) befolyásolhatják a vas anyagcseréjét és felszívódását.
- Gyógyszerek: Számos gyógyszer, amelyet az idősek gyakran szednek (pl. savcsökkentők, vérhígítók), gátolhatja a vas felszívódását vagy vérvesztést okozhat.
- Étrendi hiányosságok: Az étvágy csökkenése, a rágási nehézségek vagy a szegényes táplálkozás hozzájárulhat az elégtelen vasbevitelhez.
- Krónikus vérvesztés: Gyakoriak az emésztőrendszeri vérzések (pl. fekélyek, aranyér, daganatok), amelyek észrevétlenül is vasvesztést okozhatnak.
A vashiány hatása az idősekre:
Az időskori vashiány súlyosbíthatja az egyéb krónikus betegségek tüneteit, és rontja az életminőséget:
- Fáradtság és gyengeség: Fokozza az elesés kockázatát és csökkenti a mozgékonyságot.
- Kognitív funkciók romlása: Hozzájárulhat a memóriazavarokhoz és a demencia progressziójához.
- Gyengébb immunrendszer: Növeli a fertőzések kockázatát és lassítja a gyógyulási folyamatokat.
- Szív- és érrendszeri terhelés: A szívnek keményebben kell dolgoznia, ami súlyosbíthatja a szívbetegségeket.
Az időseknél a vashiány diagnózisa és kezelése különösen fontos a vitalitás, az önállóság és az életminőség megőrzése érdekében. Rendszeres orvosi ellenőrzés, a vérkép és a vasszint ellenőrzése, valamint szükség esetén a megfelelő vaspótlás javasolt.
Növényi étrend és vas: kihívások és megoldások
A növényi alapú étrend (vegetáriánus, vegán) számos egészségügyi előnnyel jár, de a megfelelő vasbevitel biztosítása kihívást jelenthet, mivel a növényi élelmiszerekben található nem-heme vas felszívódása alacsonyabb, mint az állati eredetű heme vasé.
A kihívások:
- Alacsonyabb felszívódási arány: Ahogy korábban említettük, a nem-heme vas felszívódása 2-20% között mozog, szemben a heme vas 20-35%-ával.
- Felszívódást gátló anyagok: A növényi élelmiszerek gyakran tartalmaznak fitátokat, oxalátokat, tanninokat és polifenolokat, amelyek gátolják a vas felszívódását.
- Nagyobb vasigény: A vegetáriánusoknak és vegánoknak a National Institutes of Health (NIH) ajánlása szerint akár 1,8-szer több vasra is szükségük lehet, mint a húsevőknek, a rosszabb felszívódás kompenzálására.
A megoldások:
A növényi étrendet követők is képesek elegendő vasat bevinni, ha tudatosan tervezik az étkezéseiket:
- C-vitaminban gazdag élelmiszerekkel együtt fogyasztás: Mindig párosítsuk a vasban gazdag növényi ételeket C-vitamin forrásokkal (pl. lencse paprikával, spenót citromlével, zabpehely bogyós gyümölcsökkel).
- Fitátok csökkentése: A hüvelyesek, gabonák és magvak áztatása, csíráztatása, fermentálása és főzése jelentősen csökkenti a fitátok mennyiségét.
- Vashoz dúsított élelmiszerek: Sok növényi tej, reggelizőpehely és kenyér vashoz dúsított, ami segíthet a napi bevitelben.
- Vaskonyhai eszközök: A vasöntvény edényekben való főzés kis mennyiségű vasat juttathat az ételekbe.
- Kerüljük a gátló anyagokat az étkezések körül: A kávét, teát, kakaót és kalcium-kiegészítőket ne fogyasszuk a vasban gazdag ételekkel egyidejűleg.
- Rendszeres ellenőrzés: A vegetáriánus és vegán étrendet követőknek érdemes rendszeresen ellenőriztetniük vasszintjüket, és szükség esetén orvosi javaslatra vaskiegészítőt szedniük.
A jól megtervezett növényi étrend bőségesen tartalmazhat vasat, de a felszívódás optimalizálása kulcsfontosságú. A tudatosság és a változatosság a siker titka.
A vas és krónikus betegségek: összefüggések és kezelési stratégiák
A vas anyagcseréjét számos krónikus betegség befolyásolhatja, és fordítva, a vashiány vagy a vasfelhalmozódás súlyosbíthatja ezeket az állapotokat. Fontos megérteni ezeket az összefüggéseket a megfelelő kezelési stratégiák kidolgozásához.
Gyulladásos bélbetegségek (IBD – Crohn-betegség, fekélyes vastagbélgyulladás):
Az IBD-ben szenvedő betegeknél a vashiány rendkívül gyakori, több okból is: krónikus vérzés az emésztőrendszerből, gyulladás okozta felszívódási zavarok, és az étvágytalanság miatti elégtelen bevitel. A gyulladás emellett a vas raktározását is befolyásolja (funkcionális vashiány). Kezelésük gyakran intravénás vaspótlást igényel.
Krónikus vesebetegség (CKD):
A CKD-ben szenvedő betegeknél gyakori a vashiány és a vérszegénység, melynek okai közé tartozik a csökkent eritropoetin termelés (a vörösvértest-termelést stimuláló hormon), a vas felszívódásának romlása, és a dialízis során fellépő vérvesztés. A vas és az eritropoetin pótlása alapvető a CKD-s betegek kezelésében.
Szívelégtelenség:
A vashiány gyakori a szívelégtelenségben szenvedő betegeknél, és súlyosbíthatja a tüneteket, mint a fáradtság és a légszomj. A vas pótlása bizonyítottan javíthatja a terhelhetőséget és az életminőséget ezeknél a betegeknél, függetlenül attól, hogy van-e vérszegénységük.
Rák:
A rákos betegeknél a vashiányos vérszegénység gyakori, melynek okai a vérvesztés, a rossz felszívódás, a gyulladásos állapot és a kemoterápia mellékhatásai. A vashiány ronthatja a beteg életminőségét, és befolyásolhatja a kezelések tolerálását.
Autoimmun betegségek:
Az olyan autoimmun betegségek, mint a rheumatoid arthritis vagy a lupus, krónikus gyulladással járnak, ami funkcionális vashiányhoz vezethet. A gyulladás miatt a ferritin szint emelkedhet, miközben a szervezetnek hiányzik a hasznosítható vas. A kezelés komplex, és a gyulladás csökkentésére is kiterjed.
Ezekben az esetekben a vaspótlásnak orvosi felügyelet mellett kell történnie, és gyakran speciális megközelítést igényel, figyelembe véve az alapbetegséget és a gyógyszeres kezeléseket.
A vas és a gyógyszerek kölcsönhatásai: mire figyeljünk?
A vasbevitel, legyen szó étrendi forrásról vagy kiegészítőről, kölcsönhatásba léphet bizonyos gyógyszerekkel, befolyásolva azok hatékonyságát vagy a vas felszívódását. Fontos tudni ezekről a kölcsönhatásokról, hogy elkerüljük a problémákat.
A vas felszívódását gátló gyógyszerek:
- Savcsökkentők (antacidok, protonpumpa-gátlók, H2-blokkolók): Ezek a gyógyszerek csökkentik a gyomor sósavtermelését, ami rontja a vas (különösen a nem-heme vas) felszívódását. Hosszú távú szedésük esetén a vashiány kockázata megnő.
- Tetraciklin és kinolon antibiotikumok: A vas megköti ezeket az antibiotikumokat, csökkentve mind a vas, mind az antibiotikumok felszívódását. Ajánlott legalább 2-4 óra különbséggel bevenni őket.
- Levotiroxin (pajzsmirigyhormon): A vas gátolhatja a levotiroxin felszívódását, ami rontja a pajzsmirigy alulműködés kezelésének hatékonyságát. Ezt a gyógyszert a vas-kiegészítőktől külön, legalább 4 óra eltéréssel kell bevenni.
Gyógyszerek, amelyeknek a vas befolyásolja a felszívódását:
- Bisztoszfonátok (csontritkulás elleni szerek): A vas csökkentheti felszívódásukat. A gyógyszert a vas-kiegészítőtől eltérő időpontban kell bevenni.
- Levodopa (Parkinson-kór gyógyszere): A vas csökkentheti a levodopa felszívódását.
Gyógyszerek, amelyek vasvesztést okozhatnak:
- NSAID-ok (nem-szteroid gyulladáscsökkentők) és vérhígítók: Hosszú távú szedésük gyomor-bélrendszeri vérzést okozhat, ami krónikus vasvesztéshez és vashiányhoz vezethet.
Mindig tájékoztassuk orvosunkat és gyógyszerészünket az összes szedett gyógyszerről és étrend-kiegészítőről, hogy elkerüljük a nem kívánt kölcsönhatásokat. A gyógyszerek és a vas-kiegészítők bevétele közötti megfelelő időeltolódás kulcsfontosságú lehet.
A vasbevitel tervezése: egyéni szükségletek figyelembe vétele
A vasbevitel tervezése nem egy „mindenkire érvényes” séma alapján történhet, hiszen az egyéni szükségletek jelentősen eltérhetnek. Az életkor, nem, életszakasz, egészségi állapot és életmód mind befolyásolja, mennyi vasra van szüksége a szervezetnek.
Az ajánlott napi vasbevitel (RDA) példák:
| Csoport | Ajánlott napi vasbevitel (mg) |
|---|---|
| Férfiak (19+ év) | 8 mg |
| Nők (19-50 év) | 18 mg |
| Nők (51+ év) | 8 mg |
| Terhes nők | 27 mg |
| Szoptató nők | 9 mg |
| Csecsemők (7-12 hónap) | 11 mg |
| Gyermekek (1-3 év) | 7 mg |
| Gyermekek (4-8 év) | 10 mg |
| Serdülők (9-13 év) | 8 mg |
| Serdülő lányok (14-18 év) | 15 mg |
| Serdülő fiúk (14-18 év) | 11 mg |
(Megjegyzés: Ezek az értékek tájékoztató jellegűek, és országonként, valamint egyéni körülmények szerint változhatnak. Vegetáriánusok és vegánok esetében az értékek magasabbak lehetnek a rosszabb felszívódás miatt.)
Az egyéni tervezés szempontjai:
- Vérvizsgálatok: A legfontosabb kiindulópont. A ferritin, transzferrin szaturáció és vérkép eredményei pontos képet adnak a jelenlegi vas státuszról.
- Étrendi szokások: Húsevő, vegetáriánus vagy vegán étrendet követ-e valaki? Mennyire változatos az étkezés?
- Életmódbeli tényezők: Sportol-e intenzíven? Van-e krónikus stressz?
- Egészségügyi állapot: Vannak-e krónikus betegségek, amelyek befolyásolják a vas anyagcseréjét vagy felszívódását? Szed-e valamilyen gyógyszert?
- Tünetek: A vashiányra utaló tünetek (fáradtság, sápadtság stb.) megléte.
A vasbevitel tervezése során mindig érdemes szakember, például orvos vagy dietetikus segítségét kérni, különösen vashiány gyanúja vagy krónikus betegségek fennállása esetén. Az öngyógyszerezés, különösen nagy dózisú vaskiegészítőkkel, veszélyes lehet.
A természetes vasforrások kiaknázása: receptek és ötletek
A vasban gazdag élelmiszerek beépítése a mindennapi étrendbe a legjobb módja a megfelelő vasszint fenntartásának. Íme néhány ötlet és recept, amelyek segítenek a természetes vasforrások kiaknázásában, figyelembe véve a felszívódás optimalizálását is.
Húsfogyasztók számára:
- Marhapörkölt C-vitaminban gazdag körettel: Készítsen egy klasszikus marhapörköltet, és tálalja mellé friss paprikasalátát vagy párolt brokkolit. A vörös hús heme vasat, a zöldségek pedig C-vitamint biztosítanak.
- Májkrém teljes kiőrlésű kenyérrel és paprikával: A máj rendkívül gazdag vasban. Készítsen házi májkrémet, és fogyassza teljes kiőrlésű kenyérrel és friss piros paprikaszeletekkel.
- Lazac spenóttal és citrommal: A lazac és a spenót is jó vasforrás, a citromlé pedig segíti a felszívódást.
Vegetáriánusok és vegánok számára:
- Lencse-csicseriborsó curry rizzsel és paradicsommal: A hüvelyesek kiváló növényi vasforrások. A paradicsom C-vitamin tartalma segíti a felszívódást. Főzés előtt áztassa be a hüvelyeseket.
- Spenótos-tökmagos saláta citrusos öntettel: A spenót és a tökmag is vasban gazdag. Készítsen belőlük salátát, és locsolja meg friss narancs- vagy citromlével készült öntettel.
- Hajdinás-brokkolis egytálétel: A hajdina és a brokkoli is tartalmaz vasat, és a brokkoli C-vitamin tartalma is magas.
- Aszalt gyümölcsös-magvas energiagolyók: Készítsen aszalt sárgabarackból, mazsolából, tökmagból és napraforgómagból energiagolyókat. Ezek nagyszerű nassolnivalók vasban gazdag alapanyagokkal. Fogyasszon hozzá egy pohár C-vitaminban gazdag gyümölcslevet.
Általános tippek a vasbevitel növelésére:
- Vashoz dúsított élelmiszerek: Válasszon vashoz dúsított reggelizőpelyheket, kenyereket vagy növényi tejeket.
- Vasöntvény edények használata: Főzzön vasöntvény edényekben, különösen savas ételeket (pl. paradicsomszósz), mert ez növeli az ételek vastartalmát.
- Kerülje a vas felszívódását gátló italokat: A kávét és teát ne fogyassza a vasban gazdag étkezésekkel egyidejűleg. Várjon legalább egy órát.
- Kiegyensúlyozott étrend: A változatos, teljes értékű étrend biztosítja a vas mellett az összes többi tápanyagot is, amely a vas optimális hasznosulásához szükséges.
A tudatos étkezéstervezéssel és a kulináris kreativitással könnyedén beilleszthetjük a vasban gazdag élelmiszereket a mindennapjainkba, hozzájárulva ezzel optimális egészségünkhöz és vitalitásunkhoz.